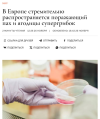
1764242910003.png

Последняя активность
-
ЧЧёрный ответил(а) в теме Европа и ее проблемы..Добровольная служба есть только во вна.
-
ЧЧёрный ответил(а) в теме Военная операция на Украине.Участки земельные новые дачники займут
-
 Haustmyrkr ответил(а) в теме Дистанционно управляемые мобильные платформы.
Haustmyrkr ответил(а) в теме Дистанционно управляемые мобильные платформы. -
 anderman ответил(а) в теме Хорошие новости.
anderman ответил(а) в теме Хорошие новости. -
 Ulan ответил(а) в теме Европа и ее проблемы..чтото я не понял. А сейчас разве во франции нет добровольный службы? или аффтар перепутал добровольную и службу по призыву?
Ulan ответил(а) в теме Европа и ее проблемы..чтото я не понял. А сейчас разве во франции нет добровольный службы? или аффтар перепутал добровольную и службу по призыву? -
 Slovak ответил(а) в теме Военная операция на Украине.А вино потом от куда брать? И золоьые поделки?
Slovak ответил(а) в теме Военная операция на Украине.А вино потом от куда брать? И золоьые поделки? -
 Slovak оставил(а) реакцию
Slovak оставил(а) реакциюLike к сообщению пользователя Бабуин382 в теме Военная операция на Украине.
Да, смайлик не поставил. Зря. -
 anderman ответил(а) в теме Смешное видео.
anderman ответил(а) в теме Смешное видео. -
 anderman ответил(а) в теме Европа и ее проблемы..Долгонько они будут готовиться. Может, хоть рации войсковые к единому стандарту приведут. А то у них на разных уровнях одного соединения...
anderman ответил(а) в теме Европа и ее проблемы..Долгонько они будут готовиться. Может, хоть рации войсковые к единому стандарту приведут. А то у них на разных уровнях одного соединения... -
 anderman ответил(а) в теме Хорошие новости.
anderman ответил(а) в теме Хорошие новости. -
 anderman ответил(а) в теме Европа и ее проблемы..
anderman ответил(а) в теме Европа и ее проблемы..